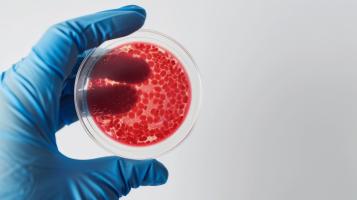
L'étude révèle un lien significatif entre le fer héminique, présent dans la viande rouge et d'autres produits d'origine animale, et le risque de diabète de type 2 (Visuel Adobe Stock 767270328)

ALIMENTATION : L’excès de sucre facteur de trouble psychiatrique ?

On sait que le sucre est un facteur d’activité cérébrale et qu’à l’instar de la plupart des nutriments, sa consommation en excès peut avoir des effets néfastes sur la santé, notamment sur la santé métabolique. Cette équipe du Tokyo Metropolitan Institute of Medical Science a regardé précisément les effets d’un apport excessif de sucre sur les fonctions cérébrales supérieures. Elle conclut, dans la revue Science Advances, qu’un régime riche en saccharose peut favoriser l'angiopathie cérébrale avec une altération de l'absorption du glucose et des dysfonctionnements cérébraux. Le stress métabolique, comme de nombreux autres types de stress environnementaux, mais pas plus, pourrait donc être en cause dans le développement de certains troubles mentaux.
La consommation de sucre simple, saccharose et sucre isomérisé (sirop de maïs converti en fructose), provenant des boissons et des aliments est en augmentation dans nos régimes occidentaux. Si comme tous les nutriments,
les sucres sans excès ont leur place dans un régime alimentaire diversifié,
les auteurs rappellent que la consommation de sucres simples est plus élevée chez les adolescents atteints de troubles mentaux. Des études ont en effet montré que les patients atteints de troubles mentaux consomment environ 2 fois plus de sucre que les personnes en bonne santé du même âge, et que chez les patients atteints de schizophrénie, des apports plus élevés de saccharose sont associés à des symptômes plus graves.
Cependant, il s’agit de données épidémiologiques et d’association, et il n’a pas été démontré à ce jour, qu'une consommation excessive de sucre contribue à la pathogenèse de troubles psychiatriques.
Une consommation excessive de sucre simple affecte-t-elle les fonctions cérébrales supérieures ?
L’étude menée chez la souris montre que l’excès de saccharose (ou sucre de table) pourrait en effet induire la psychose, chez l’animal.
- Des souris soumises à des apports excessifs de sucre présentent différents symptômes semblables à ceux de troubles mentaux, notamment une diminution de la fonction de synchronisation sensorimotrice et de la mémoire de travail et une hyperactivité. Cela suggère, toujours chez la souris, que la consommation excessive de sucre peut être un facteur de risque environnemental de troubles psychiatriques ;
- cet apport excessif de saccharose provoque des dommages cellulaires dans des groupes de cellules non neuronales, inhibant l'absorption de glucose du sang dans le parenchyme cérébral, entraînant des dysfonctionnements de certains neurones, ce qui favorise également l’apparition de symptômes de troubles psychiatriques ;
- ces souris « modèles », soumises à cet excès de sucre, présentent une « angiopathie microvasculaire cérébrale ». Cette angiopathie cérébrale est d’ailleurs retrouvée dans le cerveau post-mortem de patients atteints de schizophrénie et de trouble bipolaire ;
- enfin, cette angiopathie s'accompagne d'une altération de l'incorporation du glucose dans le parenchyme cérébral – toujours chez la souris modèle.
Ces effets cérébraux sont-ils réversibles ? Les chercheurs montrent chez des patients que ces phénotypes peuvent être prévenus par l'administration continue d'anti-inflammatoires non stéroïdiens (AINS) avant le début de la maladie. Certains symptômes de type psychiatrique ont également été supprimés. Cependant, les patients participant à l’étude n’avaient pas nécessairement d'antécédents de consommation excessive de saccharose.
Alors un impact spécifique du sucre ? Si les scientifiques japonais révèlent avec ces travaux chez la souris, des mécanismes corrélant l’excès de sucre et le développement de troubles mentaux, ils font l’hypothèse que plus largement, différents types de stress, dont le stress métabolique pouvant être induit par un excès de sucre, mais
d’autres stress aussi, peuvent favoriser le développement de troubles psychiatriques via l’angiopathie cérébrale.
Autres actualités sur le même thème
ALZHEIMER : Vers une nouvelle ère thérapeutique ?
Actualité publiée il y a 3 années 8 moisBOULIMIE : Un trouble du comportement pour la vie ?
Actualité publiée il y a 1 année 10 moisDIABÈTE : Le fer héminique de la viande rouge en question
Actualité publiée il y a 1 année 6 moisRÉGIME VÉGÉTALIEN : Il faut veiller à sa santé osseuse
Actualité publiée il y a 3 mois 6 jours
ABONNEMENT PREMIUM
Accédez sans limite à plus de 15 000 actualités